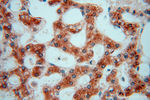
PDIR Antibody in Immunohistochemistry (Paraffin) (IHC (P))

Search
Proteintech
PDIR Polyclonal Antibody
{{$productOrderCtrl.translations['antibody.pdp.commerceCard.promotion.promotions']}}
{{$productOrderCtrl.translations['antibody.pdp.commerceCard.promotion.viewpromo']}}
{{$productOrderCtrl.translations['antibody.pdp.commerceCard.promotion.promocode']}}: {{promo.promoCode}} {{promo.promoTitle}} {{promo.promoDescription}}. {{$productOrderCtrl.translations['antibody.pdp.commerceCard.promotion.learnmore']}}
产品信息
15545-1-AP
种属反应
已发表种属
宿主/亚型
分类
类型
抗原
偶联物
形式
浓度
规格
纯化类型
保存液
内含物
保存条件
运输条件
产品详细信息
Immunogen sequence: MARAGPAWL LLAIWVVLPS WLSSAKVSSL IERISDPKDL KKLLRTRNNV LVLYSKSEVA AENHLRLLST VAQAVKGQGT ICWVDCGDAE SRKLCKKMKV DLSPKDKKVE LFHYQDGAFH TEYNRAVTFK SIVAFLKDPK GPPLWEEDPG AKDVVHLDSE KDFRRLLKKE EKPLLIMFYA PWCSMCKRMM PHFQKAATQL RGHAVLAGMN VYSSEFENIK EEYSVRGFPT ICYFEKGRFL FQYDNYGSTA EDIVEWLKKV WPL (1-262 aa encoded by BC001625)
靶标信息
PDIR (protein disulfide isomerase-related protein) is a novel PDI protein that was originally isolated from a human placental cDNA library. It has been suggested that from its nucleotide sequence, PDIR has three CXXC-like motifs (Cys-Ser-Met-Cys, Cys-Gly-His-Cys and Cys-Pro-His-Cys), which are found in the PDI superfamily of proteins. The CXXC motif is responsible for oxidoreductase activity. PDIR is also shown to have a putative endoplasmic reticulum (ER) retention signal 'Lys-Glu-Glu-Leu' at its carboxyl terminus, indicative of ER resident proteins. Northern blot analysis of PDIR indicates that it is preferentially expressed in cells actively secreting proteins. It has also been shown that expression of PDIR is stress-inducible. Data suggest that PDIR, like other PDIs, has oxidoreductase activity of disulfide bonds and facilitates the protein folding process within the lumen of the ER.
仅用于科研。不用于诊断过程。未经明确授权不得转售。
生物信息学
蛋白别名: protein disulfide isomerase A5; protein disulfide isomerase-associated 5; Protein disulfide isomerase-related protein; Protein disulfide-isomerase A5
基因别名: 2700053F16Rik; AU015525; PDIA5; PDIR
UniProt ID: (Human) Q14554, (Mouse) Q921X9, (Rat) Q5I0H9
Entrez Gene ID: (Human) 10954, (Mouse) 72599, (Rat) 360722